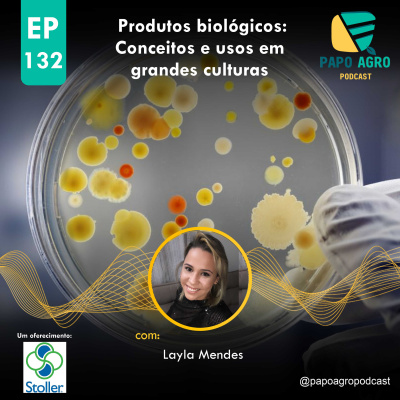
Papo Agro Podcast: Vamos Falar Sobre O Agro?

Papo Agro Podcast: Vamos Falar Sobre O Agro?
PA132 - Produtos Biológicos: Conceitos e usos em grandes culturas
- Autor: Vários
- Narrador: Vários
- Editora: Podcast
- Duração: 0:28:27
- Mais informações
Informações:
Sinopse
Neste episódio contamos com a presença da Eng. Agrônoma Layla Mendes ( @layloca_mm ) para conversar sobre os produtos biológicos e seus usos em grandes culturas. Virus, bactérias e fungos agindo em associação com as plantas de forma a beneficiar as lavoras e produtores rurais. Bora Ouvir? Quer saber mais? Então corre lá na sua plataforma de áudio favorita e confira o episódio novo!Nossa Rede de Parceiros:Rede Agrocast:@redeagrocastAcademia do Agro:@academiadoagroAgro Resenha:@agroresenhaBendito Agro:@benditoagroBug Bites:@bugbitespodcastCachaça, Prosa & Viola:@cpvpodcastEsalqast:@esalqastMundo Agro Podcast:@mundoagropodcastNotícias do Front:@noticias_do_frontPapo Agro:@papoagropodcastRumenCast:@rumencastDicionário Agro: @dicionario.agroTatu da Fruta podcast: @tatudafruta#papoagropodcast #podcastdoagro #agro #papoagro #podcast #milho #soja #fungos #virus #bacterias